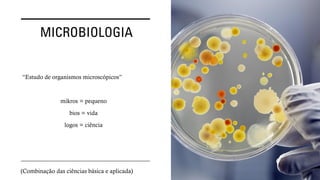
MICROBIOLOGIA
“Estudo de organismos microscópicos”
mikros = pequeno
bios = vida
logos = ciência
(Combinação das ciências básica e aplicada)
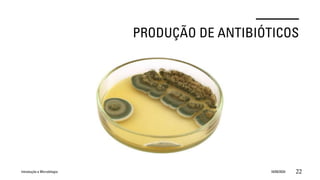
PRODUÇÃO DE ANTIBIÓTICOS
Introdução a Microbilogia 16/09/2024 22

O documento aborda o conteúdo da disciplina de Microbiologia, incluindo a evolução, morfologia, nutrição, metabolismo e controle de microrganismos. Discute a importância dos microrganismos tanto benéficos, como na produção de alimentos e antibióticos, quanto prejudiciais, como agentes de doenças. Além disso, apresenta detalhes sobre avaliações, provas e bibliografia recomendada para os alunos.